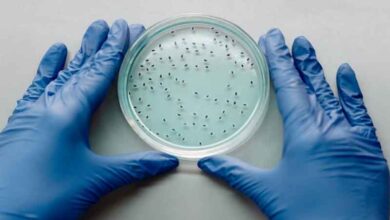

اخبار
کریستیانو رونالدو از هم تیمی هایش حمایت کرد

ستاره پرتغالی النصر که در دیدار رفت برابر استقلال غایب بود، از هم تیمی هایش حمایت کرد و به نوعی برای بازی برگشت اعلام آمادگی کرد.
کریستیانو رونالدو، کاپیتان النصر، پس از تساوی تیمش برابر استقلال ایران در مرحله یک هشتم نهایی لیگ نخبگان آسیا، با انتشار یک استوری در اینستاگرام، به هم تیمی هایش روحیه داد.
رونالدو که به دلیل مصدومیت تیمش را در سفر به تهران همراهی نکرده بود، تصویری از شادی بازیکنان النصر را منتشر کرد و با نوشتن جمله “Let’s go Al-Nassr”، حمایت خود را از تیم نشان داد. این واکنش ستاره پرتغالی، به نوعی انگیزه ای برای شاگردان استفانو پیولی محسوب می شود که باید در دیدار برگشت به دنبال کسب پیروزی و صعود به مرحله یک چهارم نهایی باشند.